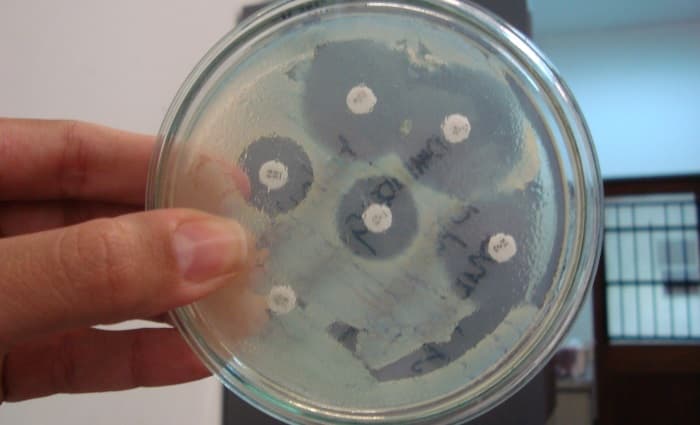
Mold Testing

Whether your home is on the market, or you’re looking to buy, one of the most nerve wracking moments of the process is likely to be the Home Inspection. As the home inspector combs through the property, thoroughly looking for issues that could present a problem for the new owners, the likelihood is that they will find something. But what if they found Mold? Is it a deal breaker?
What is Mold?
Mold is a living organism that essentially spreads to and colonizes new areas of a home as they become conducive to their preferred growing environment.
Mold only needs a few things to grow:
• And time (3 to 5 days is plenty)
If you think about it, this really isn’t much… The easiest way to prevent mold growth within a structure is by controlling moisture and responding quickly to moisture issues.
Is Mold a deal breaker?
No. While severity certainly plays a roll here, there is generally no reason to consider Mold a deal breaker. As part of the mold remediation project, the moisture issue that caused the problem in the first place should be resolved, eliminating the potential for future mold growth.
Having mold growth in a property does not mean that you will have mold problems in the future. In fact, provided the underlying cause has been corrected, the prior existence of mold does not make this property any more likely to have an issue in the future than any other property. This is why we at Disaster Blaster work with the homeowner to ensure that any necessary repairs are performed as part of the mold remediation project.
How severe is the Mold Contamination?
With Mold contamination, severity is determined by several different factors, including the number of rooms or areas affected, the extent of visible mold growth, the likelihood of wall cavities and other hidden areas being contaminated, and the overall condition of the property. A professional Mold Remediation Company will be able to inspect the property, investigating likely locations and causes for contamination, and will be able to prepare a detailed proposal for addressing the mold issue.
What else should I consider?
Proper Mold Remediation requires special training and knowledge. Look for companies that have been performing Mold Remediation for a long time and who have a good reputation in the industry (We at Disaster Blaster have been performing Mold Remediation for 20 years). As mold is an exclusion under General Liability Insurance Policies, your Mold Remediation Company should be properly insured under a Pollution Liability Policy in order to provide mold remediation services, and should be able to provide you with proof of this coverage upon request (Disaster Blaster is properly insured).
It is also important to consider any additional steps, such as post testing and repairs that may be necessary, and to allow enough time for those services to be completed as well. It is always recommended to have an independent 3rd party perform any necessary testing services. Recognizing that testing your own work is a significant conflict of interest, Disaster Blaster does not perform its own testing.
What about repairs and additional steps?
Due to potential for mold growth to exist in wall cavities and hidden areas, it isn’t until the mold remediation is completed that you can determine what Repairs may be necessary. Once the mold remediation has been completed, and the mold remediation company has cleared the area for other contractors to enter, you can begin getting estimates for the repairs that may be necessary. Many Mold Remediation Companies are able to also handle the repairs and can prepare an estimate for this work as well.
If you have elected for Post Testing, doing so while you are waiting for the repair estimates is a great use of time. Please note that, while uncommon, it is possible that additional mold remediation steps may become necessary following post testing. If additional steps are necessary, this additional work would need to be completed before the repairs began.
How long does the Mold Remediation Process take?
Due to the drastic differences in the severity of mold remediation projects, the duration of the remediation services can vary greatly. For this reason, it is best to get an estimated timeframe for your specific project from the Mold Remediation Company that is performing the work. Once the active mold remediation services are completed however, air scrubbing to remove mold spores in the air, must be performed and generally takes around 3 additional days.
Testing services generally take a full week from the date samples are taken to the report being completed and returned. There are factors that can affect this timeframe, so it is always best to get an accurate estimate from the mold tester.
Repairs can vary greatly depending on how much work is necessary and whether any items are special order. When getting estimates for the repair services, it’s always a good idea to get a timeframe from the contractor and to also ask them when they would be available to start. Due to the limitations on time that a closing often creates, it is important to ensure that your contractor is able to begin the project timely.
We hope you found this information helpful! As each mold issue is unique, it is always best to contact a qualified Mold Remediation Company in order to get accurate and specific recommendations and information. Having been the first company in Northeastern PA to offer Mold Remediation Services, our offices are uniquely qualified to assist you and are always happy to help. Please don’t hesitate to Contact your local Disaster Blaster office should your home inspector find anything that we can assist you with!
*This information is provided for informational purposes only and may not be representative of your unique situation. We encourage you to contact your local Disaster Blaster office so that we may make recommendations specific to your situation. This information is not intended as legal advice.
Interested in older news stories? Please see our Archive.